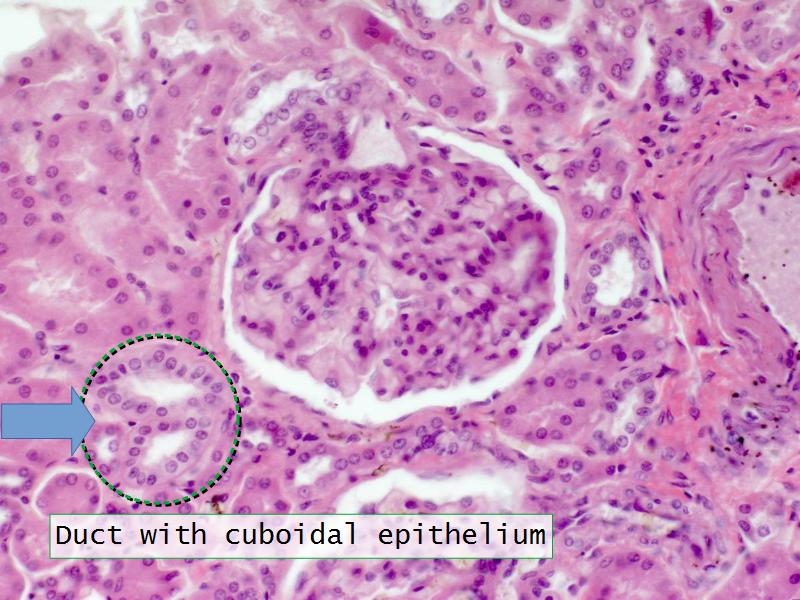
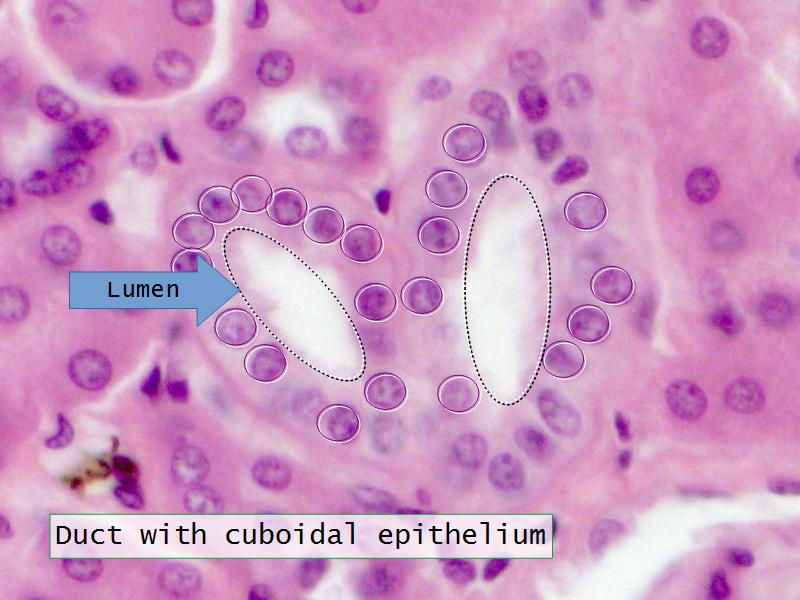

- esc key shows all the slides
- arrows left right advance the slide
- mobile device swipe left right
- slides can go left-right and up-down
- ? gives instant help
- menu bottom left
- Have a pen & paper ready
- Answer every question
- Mark your answer after answering
- Elaborate on each answer
- Add relevant clinical content
- If you have trouble, ask
Kidney
And
Oral Cavity




















Q13: Name 1 epithelium for each.
- Kidney =
- Liver =


















Q13: Name 1 epithelium for each.
- Kidney = cuboidal, squamous
- Liver = squamous, cuboidal








Kidney
Slides 28 & 76
Kidney: Objectives
- Basic anatomy of the kidney
- Basic arrangement of nephrons and collecting tubules in the kidney
- Structure of the nephron and collecting tubules
- The renal corpuscle
Kidney: Tasks
- Make an annotated drawing of the macroscopic view of the kidney.
- Make an annotated diagram of a nephron, including the juxtaglomerular apparatus. Indicate the flow of blood and water in each part, and how solutes are filtered, secreted and reabsorbed.
- Complete the drawings for each slide in the practical workbook.
Macroscopic
Anatomy
Of the
Kidney

Nephron

The End
Save Document
- Click the link above
- Print to PDF
Works best using Google Chrome
Others Browser YMMV